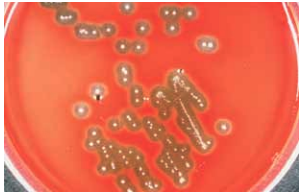

How Do Organisms Reproduce?
Reading from SEPUP - Genetics: What is the Difference Between Sexual and Asexual Reproduction?
Every human is the child of two biological parents. Most organisms that you are familiar with, like the kittens in the photo, are also the offspring of two parents. They have certain features of both parents, but are not exactly like either parent. Some organisms however, are the offspring of only one parent. They reproduce by making an exact copy of themselves. In this activity, you will read about how different organisms reproduce.
![]()
Asexual Reproduction
If you go to an art gallery, you might see an art historian inspecting a work of art, trying to determine whether it is the original or a “reproduction.” A reproduction may not be a perfect copy of the original, but it’s close.
Organisms reproduce in two ways. Some organisms can use asexual reproduction (in which they make exact copies of themselves). A single-celled organism, such as a bacterium or an amoeba, reproduces by dividing in two (see figure below). Each new organism produced (offspring) is identical to the parent cell.
Organisms reproduce in two ways. Some organisms can use asexual reproduction (in which they make exact copies of themselves). A single-celled organism, such as a bacterium or an amoeba, reproduces by dividing in two (see figure below). Each new organism produced (offspring) is identical to the parent cell.
![]()
In asexual reproduction of a bacterial cell, is it clear which cell is the parent and which is the offspring? Explain.
Asexual Reproduction (continued)
These two identical offspring are both called clones of the single parent organism. A clone inherits all of its traits from its one parent. Each clone has identical traits, except in rare cases when a random change occurs. Imagine copying a sentence and making a small mistake. In the same way, a gene can be reproduced slightly differently from the original gene. This change can cause the offspring cell to have a different trait from the parent cell. This type of random change is known as a mutation.
Bacterial Clones

Strawberry Plant

The strawberry plant can also reproduce asexually, by generating tiny new plants on a rootlike runner. Each of these little plants can eventually separate from the parent and become a new individual identical to its parent. Any organism that is produced through asexual reproduction can be considered a clone, since it inherits all its traits from one parent.
Your friend tells you, “Only single-celled organisms reproduce asexually. After all, how could a multicellular organism do that?” How do you respond to your friend?
Sexual Reproduction
Most animals and plants can also reproduce by sexual reproduction. In fact, humans and many other animals can only reproduce sexually. Such organisms inherit traits from two parents, not one. You are not a perfect copy of either of your parents. You also are not a perfect blend of your parents’ traits.
What determines which traits you get from each parent?
Sexual Reproduction (continued)
Sexual reproduction occurs when a tiny sperm cell produced by a male unites with an egg cell produced by a female, as shown to the right. The union of the sperm and the egg is called fertilization.
The cell that results will have genes from both the egg and the sperm. Because genes help to determine traits, sexual reproduction produces a new cell that develops into an individual with traits inherited from both parents. This new individual will be different from each of its biological parents. Also, because no two sperm or egg cells contain exactly the same information, no two offspring produced by the same parents are identical. A unique set of inherited genes means a unique set of inherited traits.

There is an exception to the last statement: identical twins. Identical twins result when one fertilized egg splits before beginning to grow and develop— the two eggs then become two genetically identical offspring or children. Only one fertilization occurs, but two organisms are produced. Asexual and sexual reproduction are summed up in the table below.

"Fraternal twins" result when two eggs are both fertilized by sperm cells, and both develop offspring. Why are identical twins much more similar that fraternal twins? Use your best thinking right now to explain your response.
Cloning
There is an exception to the last statement: identical twins. Identical twins result when one fertilized egg splits before beginning to grow and develop— the two eggs then become two genetically identical offspring or children. Only one fertilization occurs, but two organisms are produced. Asexual and sexual reproduction are summed up in the table below.
Scientists have now produces certain organisms artificially through a type of asexual reproduction. Consider the cloning of a sheep, illustrated in the figure below. The part of the cell that contains the genes (the mucleus) is removed from one of the cells in the sheep's body. This nucelus is placed into an egg cell whose nucelus has already been removed. If this artificially fertilized egg develops in a womb, it grows into a sheep that is genetically identical to the sheep that its nucleus came from. It is therefore a clone of that sheep.

How is a clone different from an identical twin?
Classify each of the following as either sexual or asexual reproduction. Explain your answer in the show your work section.
| Draggable item | arrow_right_alt | Corresponding Item |
|---|---|---|
A small worm that lives in water splits in two and each half grows to normal size. The head end grows a tail, and the tail end grows a head. | arrow_right_alt | |
An orange cat is mated with a black cat, in hopes of producing a tortoiseshell cat. | arrow_right_alt | |
A male fish releases sperm cells into the water. One of the sperm cells unites with an egg from a female fish to form a new cell that grows into a new fish. | arrow_right_alt | |
Sheep reproduce only by sexual reproduction in nature. Using modern technology, a clone of an adult sheep is produced. | arrow_right_alt | |
A red-flowered geranium with dull leaves is bred with a whiteflowered geranium with shiny leaves, with a goal of producing a red-flowered geranium with shiny leaves. | arrow_right_alt | |
A cutting is taken from a red-flowered geranium and placed in water to develop roots. Once roots have grown, the new plant is placed in soil and grows to produce another red-flowered geranium. | arrow_right_alt |
In the work space here, on paper, or in another way, create a Venn diagram comparing sexual and asexual reproduction. (Ask your teacher how to share your response, if you don't use the space below.)
If you were given an opportunity to clone yourself, would you do it? Explain your thinking in the space below.